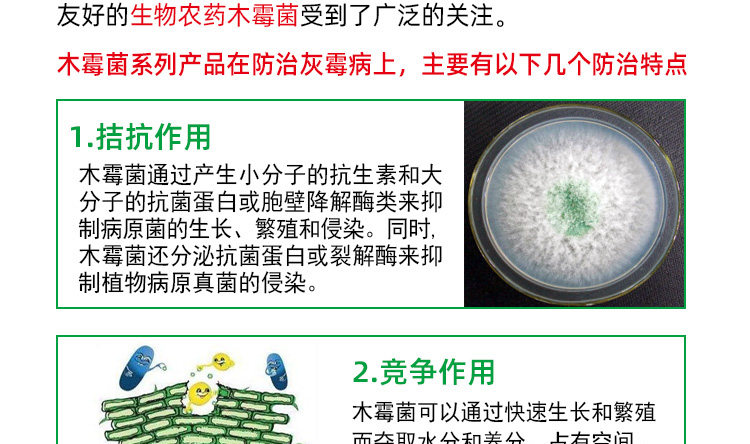

200 миллионов зеленого дерева огурцы огурцы томатные томатные томаты серая плесень Бактерицидная биологическая говядина пестицидов Доктор Органические

Цена: 180-2 695руб. (¥8.5)
Артикул: 532585885220
Вес товара: ~0.7 кг. Указан усредненный вес, который может отличаться от фактического. Не включен в цену, оплачивается при получении.
Описание товараPGRpdj48aW1nIHNyYz0iaHR0cHM6Ly9pbWcuYWxpY2RuLmNvbS9pbWdleHRyYS9pNC8yODEzNzkwODc1L08xQ04wMTNwYm9ObjFJS25BdTJjYnhzXyEhMjgxMzc5MDg3NS5qcGciPjwvZGl2PjxkaXY+PGltZyBzcmM9Imh0dHBzOi8vaW1nLmFsaWNkbi5jb20vaW1nZXh0cmEvaTEvMjgxMzc5MDg3NS9PMUNOMDFZVXR2aGsxSUtuQW90WU1IVF8hITI4MTM3OTA4NzUuanBnIj48L2Rpdj48ZGl2PjxpbWcgc3JjPSJodHRwczovL2ltZy5hbGljZG4uY29tL2ltZ2V4dHJhL2kxLzI4MTM3OTA4NzUvTzFDTjAxeXFMWXdXMUlLbkROM1BmNTRfISEyODEzNzkwODc1LmpwZyI+PC9kaXY+PGRpdj48aW1nIHNyYz0iaHR0cHM6Ly9pbWcuYWxpY2RuLmNvbS9pbWdleHRyYS9pMS8yODEzNzkwODc1L08xQ04wMTNiUDBqUDFJS25ES2tOclRvXyEhMjgxMzc5MDg3NS5qcGciPjwvZGl2PjxkaXY+PGltZyBzcmM9Imh0dHBzOi8vaW1nLmFsaWNkbi5jb20vaW1nZXh0cmEvaTMvMjgxMzc5MDg3NS9PMUNOMDF1QzZOamcxSUtuREk5V1JJWV8hITI4MTM3OTA4NzUuanBnIj48L2Rpdj48ZGl2PjxpbWcgc3JjPSJodHRwczovL2ltZy5hbGljZG4uY29tL2ltZ2V4dHJhL2kyLzI4MTM3OTA4NzUvTzFDTjAxYVdVaWxKMUlLbkRSQUFuUWtfISEyODEzNzkwODc1LmpwZyI+PC9kaXY+PGRpdj48aW1nIHNyYz0iaHR0cHM6Ly9pbWcuYWxpY2RuLmNvbS9pbWdleHRyYS9pNC8yODEzNzkwODc1L08xQ04wMU9tSE1GTzFJS25ERDU4cUhBXyEhMjgxMzc5MDg3NS5qcGciPjwvZGl2PjxkaXY+PGltZyBzcmM9Imh0dHBzOi8vaW1nLmFsaWNkbi5jb20vaW1nZXh0cmEvaTQvMjgxMzc5MDg3NS9PMUNOMDFrdWRSOTUxSUtuRFJBQzhhQl8hITI4MTM3OTA4NzUuanBnIj48L2Rpdj48ZGl2PjxpbWcgc3JjPSJodHRwczovL2ltZy5hbGljZG4uY29tL2ltZ2V4dHJhL2kyLzI4MTM3OTA4NzUvTzFDTjAxaTBmeW9iMUlLbjlUYm8yWGVfISEyODEzNzkwODc1LmpwZyI+PC9kaXY+PGRpdj48aW1nIHNyYz0iaHR0cHM6Ly9pbWcuYWxpY2RuLmNvbS9pbWdleHRyYS9pMi8yODEzNzkwODc1L08xQ04wMTc3UG1TTjFJS245VTNzNWtpXyEhMjgxMzc5MDg3NS5qcGciPjwvZGl2PjxkaXY+PGltZyBzcmM9Imh0dHBzOi8vaW1nLmFsaWNkbi5jb20vaW1nZXh0cmEvaTEvMjgxMzc5MDg3NS9PMUNOMDFyTWxuQ2QxSUtuOVlpbnc4bF8hITI4MTM3OTA4NzUuanBnIj48L2Rpdj48ZGl2PjxpbWcgc3JjPSJodHRwczovL2ltZy5hbGljZG4uY29tL2ltZ2V4dHJhL2kzLzI4MTM3OTA4NzUvTzFDTjAxTHlnS2hpMUlLbkN3djYxa2xfISEyODEzNzkwODc1LmpwZyI+PC9kaXY+PGRpdj48aW1nIHNyYz0iaHR0cHM6Ly9pbWcuYWxpY2RuLmNvbS9pbWdleHRyYS9pMi8yODEzNzkwODc1L1RCMmhibGFjS3VTQnVOankxWGNYWGNZakZYYV8hITI4MTM3OTA4NzUuanBnIj48L2Rpdj48ZGl2PjxpbWcgc3JjPSJodHRwczovL2ltZy5hbGljZG4uY29tL2ltZ2V4dHJhL2kyLzI4MTM3OTA4NzUvTzFDTjAxRm5WOTJNMUlLbkUwYm44NzFfISEyODEzNzkwODc1LmpwZyI+PC9kaXY+PGRpdj48aW1nIHNyYz0iaHR0cHM6Ly9pbWcuYWxpY2RuLmNvbS9pbWdleHRyYS9pNC8yODEzNzkwODc1L08xQ04wMXFmdzZ5MzFJS25Dd28zOE9kXyEhMjgxMzc5MDg3NS5qcGciPjwvZGl2Pg==
Продавец:山东泰诺药业有限公司
Рейтинг:

Всего отзывов:0
Положительных:0
Выберите вариацию / цвет
- 5kg
- 100g
Добавить в корзину
- Информация о товаре
- Фотографии
| Чистый контент: | 100g, 5kg |